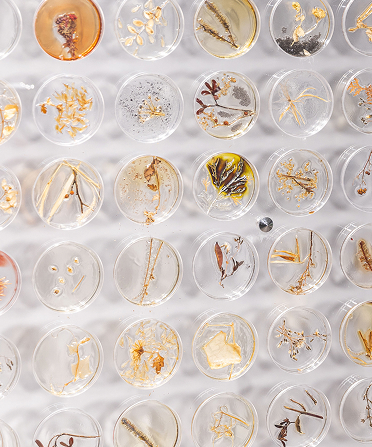

Explore the future-forward vision and emerging landscape of life sciences proposed by ODC through press kit
We provide a cohesive set of official brand assets that strengthen and elevate your storytelling.

Please review your details before submitting your registration for ODC25. Make sure everything is accurate to ensure a smooth registration process.